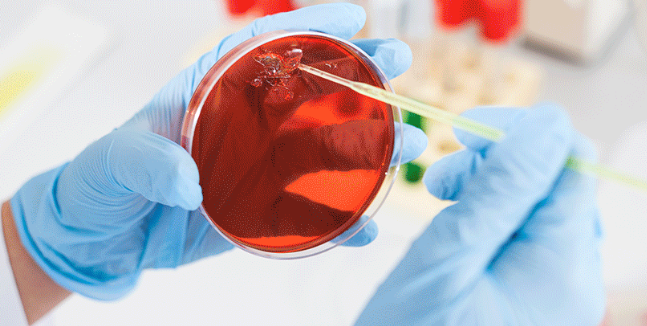

Specjalista ds. Jakości
27.03.2023 | 1 min. czytania
Jesteśmy największą w Polsce firmą świadczącą niezależne usługi w zakresie badań i ekspertyz jakościowych, dysponującą siecią akredytowanych laboratoriów analitycznych.
Dla naszych klientów z wielu branż oferujemy szeroki wachlarz wyspecjalizowanych analiz żywności, kosmetyków i produktów chemii gospodarczej, farmaceutyków, opakowań i artykułów przemysłowych, paliw ciekłych i stałych i wielu innych.
J.S. HAMILTON POLAND Sp. z o.o. posiada ponad 10 oddziałów w Polsce oraz na rynku zagranicznym. Łącznie zatrudnia ponad 800 osób.
Specjalista ds. Jakości Miejsce pracy: GdyniaOpis stanowiska:
- Rozpatrywanie reklamacji, monitorowanie zadowolenia klienta
- Koordynowanie i wdrażanie działań korygujących
- Wsparcie Działu Zarządzania Jakością
- Udział w tworzeniu dokumentacji jakościowej
- Współpracę z działami w zakresie doskonalenia Systemu Zarządzania Jakością
- Analizy, weryfikacje istniejących procesów oraz rekomendowanie działań usprawniających
- Standaryzacje i utrwalanie wdrożonych rozwiązań
Wymagania:
- Wykształcenie wyższe: Zarządzanie Jakością, Towaroznawstwo oraz pokrewne
- Doświadczenie w pracy w laboratorium na podobnym stanowisku
- Komunikatywny j. angielski
- Znajomość: PN-EN ISO/IEC 17025:2018-02; PN-EN ISO 9001: 2015
- Dobra organizacja czasu pracy oraz umiejętność pracy w grupie
- Samodzielność w rozwiązywaniu problemów analitycznych
- Umiejętność pracy w zespole także pod presją czasu
- Wielozadaniowość, umiejętność ustalania priorytetów
- Znajomość programów Word, Excel
- Komunikatywność, asertywność, odporność na stres
Co możemy Ci zaoferować:
- Umowę o pracę z wypłatą na czas
- Pakiet medyczny
- Ubezpieczenie na życie
- Dofinansowanie do karty Multisport
- Benefity w ramach ZFŚS (dofinansowanie do wczasów, imprezy okolicznościowe dla dzieci)
- System poleceń
- Dostęp do platformy Kafeteryjnej MyBenefit
- Wewnętrzne szkolenia
Zainteresowało Cię to ogłoszenie?
Z Biurem Karier Studenckich przygotujesz swoje dokumenty aplikacyjne oraz przygotujesz się do rozmowy rekrutacyjnej.
UMÓW SIĘ NA SPOTKANIE

